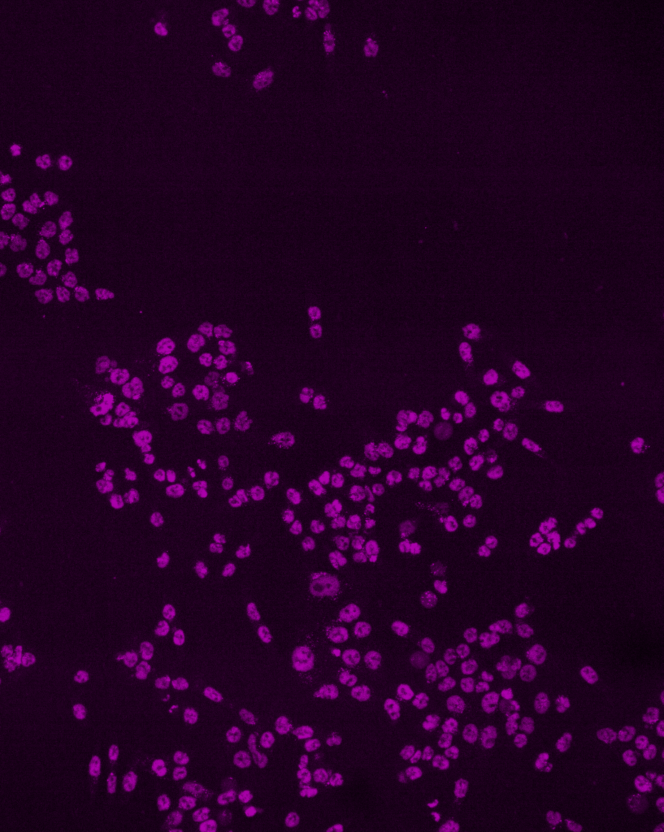

Technical experience
Implemented across several research institutions, these techniques span advanced microscopy, signalling assays, cell imaging, and animal behaviour.
Establishing and refining experimental techniques is a real joy of mine and has enabled our research to be robust and reliable.
RNA polymerase II project

smFISH
ImagingSingle-molecule fluorescence in-situ hybridisation (or smFISH) uses oligonucleotide probes to visualise single RNA transcripts as discrete, countable spots.

Live cell fluorescence
Human cells are genetically edited to express tagged proteins which can then be monitored in live cells over many hours.
Imaging


FRAP
Fluorescence recovery after photobleaching (FRAP) employs laser-scanning confocal imaging to assess protein dynamics. In this exampl, FRAP is performed on RNA polymerase II in human cell nuclei.

High-content imaging
ImagingLarge experiments performed in multi-well (18, 96, 384) plates, combining immunofluorescence, fluorescent proteins, cell stains, DNA stains, and click-chemistry visualisation of nascent RNA (EU).
Single-particle tracking
ImagingImaging at high resolution with very high frame-rates allows the tracking of individual particles through time. This gives exquisite sensitivity into the diffusive behaviour of individual molecules, for example of RNA polymerase II, as these proteins carry out functions in the cell.
ImagingInducible degron systems
Editing genomes of cell lines, for instance using CRISPR/Cas9-directed homology directed repair, to express endogenous proteins with inducible degron tags. This allows precise and rapid manipulation of cellular systems. See Yesbolatova et al. 2020, Nabet et al. 2015, Buckley et al. 2015.
Genetic engineeringOpioid receptor signalling project

Signalling assays
High throughputThese assays use fluorescence, or bioluminescence, to assess receptor activity or ligand binding, and usually occur in a high-throughput format.
Crucially, these live-cell assays are rapid and kinetically sensitive.


Single-cell patch clamp
Electrophysiology This approach involves making electrical access to a whole cell, and can be used to assess a wide variety of aspects of biology. The coupling of receptors to ion channels makes this a readout of receptor activation with incredible kinetic sensitivity.
Receptor immunofluorescence
Imaging Staining receptors expressed in human cells via immunofluorescence allows assessment of their localisation, and how this may change following treatment.



Anti-nociception and analgesia
In vivoCommon animal models of analgesia, or anti-nociception (pain perception), include the hot-plate test, tail-flick test, and von Frey filament assay.
Whole-body plethysmography
In vivoA technique which allows the assessment of respiratory parameters, such as breathing frequency and tidal volume, without necessitating restraint of an animal. Can be complemented by pulse oximetry.
Nerve injury models
In vivoIn order to understand chronic pain, and develop analgesics which target this poorly treated condition with better efficacy, models of nerve pain in animals are used.
A common surgically induced model of neuropathic pain is chronic constriction injury (CCI) of the sciatic nerve.